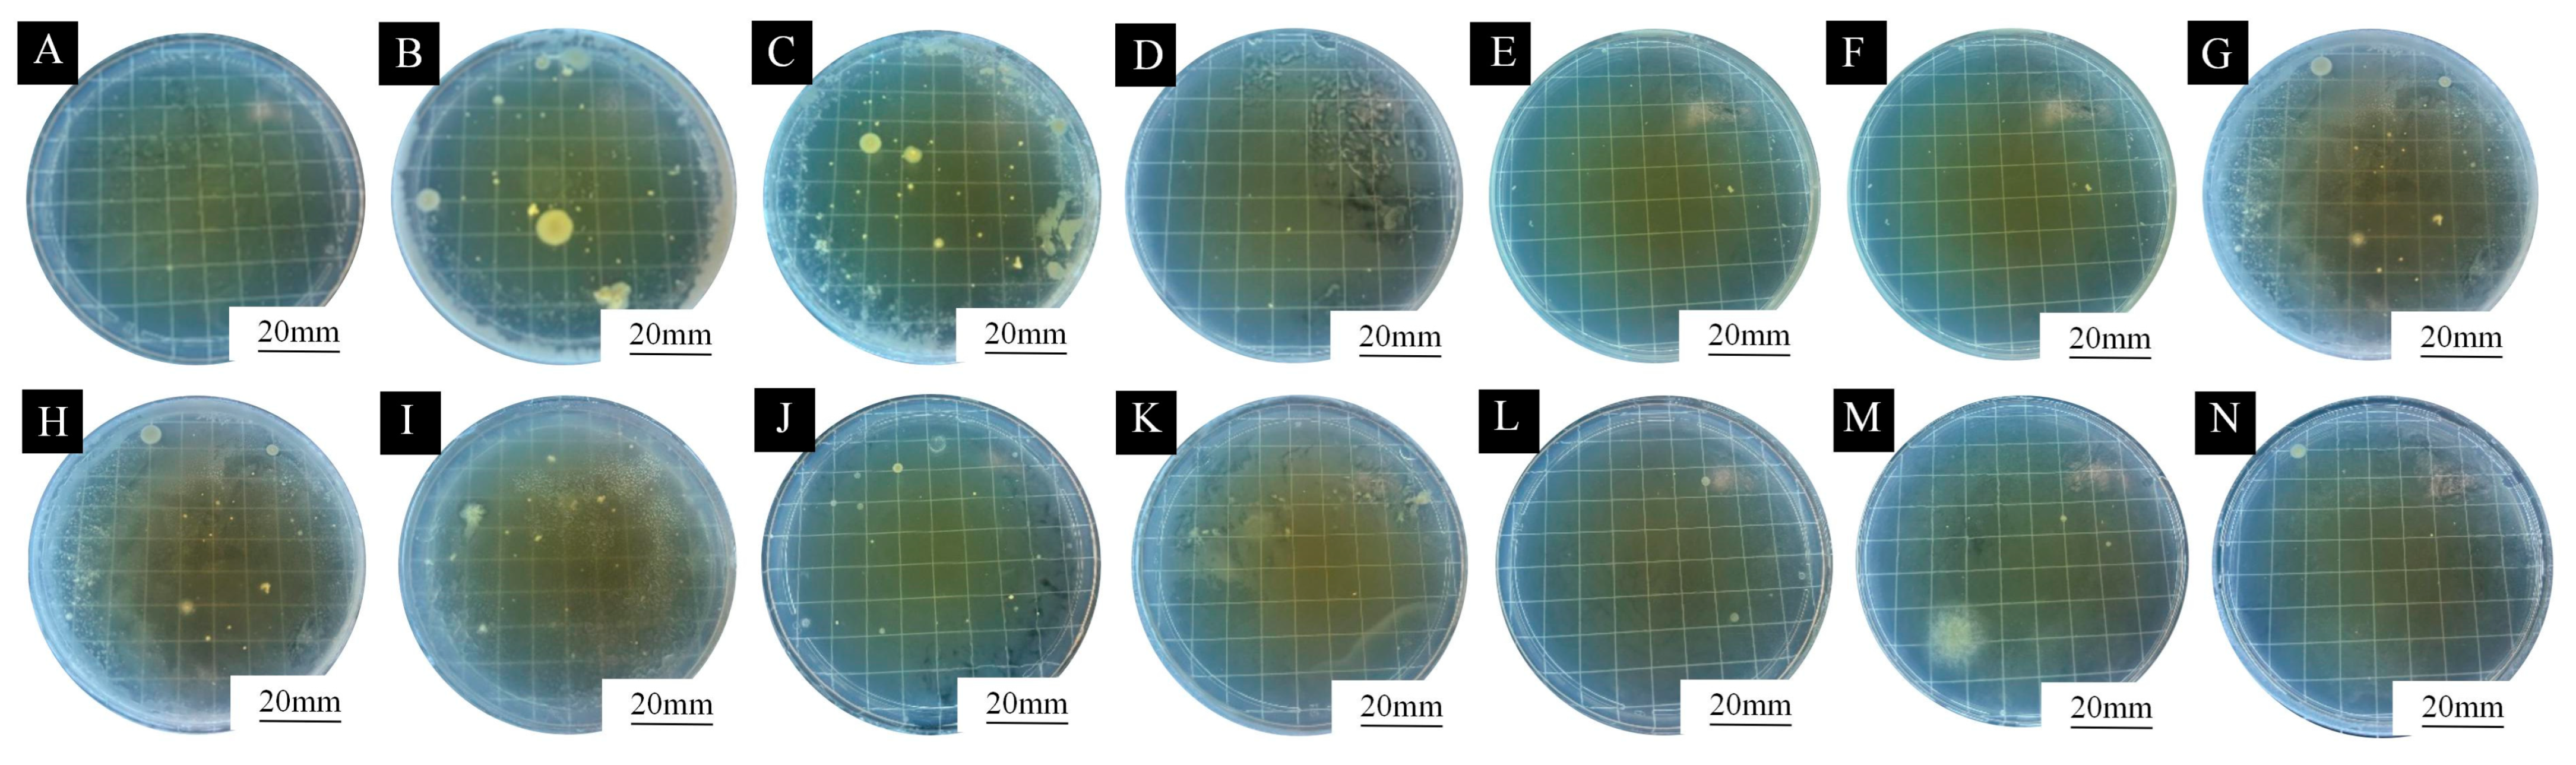
Coatings 15 01105 g008

Preparation of Tea Tree Essential Oil@Chitosan-Arabic Gum Microcapsules and Its Effect on the Properties of Waterborne Coatings
Abstract
1. Introduction
2. Methods and Test Materials
2.1. Test Materials
2.2. Preparation of Microcapsules and Experimental Design
2.3. Preparation of Waterborne Coatings with TTO@CS-AG Microcapsules
2.4. Test and Characterisation
2.4.1. Yield and Encapsulation Rate Testing
2.4.2. Microscopic Morphology
2.4.3. Chemical Composition Test
2.4.4. Antimicrobial Performance Test
2.4.5. Optical Performance Test
2.4.6. Mechanical Performance Test
3. Results and Discussion
3.1. Analysis of Yield and Encapsulation Rate of TTO@CS-AG Microcapsules
3.2. Micro-Morphological Analysis of TTO@CS-AG Microcapsules
3.2.1. Microcosmographic Analysis of Microcapsules
3.2.2. Analysis of the Chemical Composition of Microcapsules
3.3. Morphology and Chemical Composition Analysis of TTO@CS-AG Microencapsulated Waterborne Coating
3.4. Analysis of Antimicrobial Properties of Microcapsules with Different mAG:mCS on Coating
3.5. Analysis of Microcapsules with Different mAG:mCS on the Optical Properties of Coating
3.5.1. Colour Difference Performance Analysis
3.5.2. Gloss and Loss Performance Analysis
3.5.3. Visible Light Transmission Rate Analysis
3.6. Analysis of Microcapsules with Different mAG:mCS on Mechanical Properties of Coating
3.6.1. Roughness Performance Analysis
3.6.2. Mechanical Properties Analysis
4. Conclusions
Author Contributions
Funding
Institutional Review Board Statement
Informed Consent Statement
Data Availability Statement
Conflicts of Interest
References
- Zhou, J.; Xu, W. Optimizing the Interface Compatibility of Transparent Wood for Green Phase-Change Thermal Storage. Wood Sci. Technol. 2025, 59, 45. [Google Scholar] [CrossRef]
- Yang, Y.; Xu, W.; Liu, X.; Wang, X. Study on Permeability of Cunninghamia Lanceolata Based on Steam Treatment and Freeze Treatment. Wood Res. 2021, 66, 721–731. [Google Scholar] [CrossRef]
- Wu, S.; Tao, X.; Xu, W. Thermal Conductivity of Poplar Wood Veneer Impregnated with Graphene/Polyvinyl Alcohol. Forests 2021, 12, 777. [Google Scholar] [CrossRef]
- Liu, X.; Cui, R.; Shi, J.; Jiang, Q.; Gao, J.; Wang, Z.; Li, X. Separation and microencapsulation of antibacterial compounds from wood vinegar. Process Biochem. 2021, 110, 275–281. [Google Scholar] [CrossRef]
- Bi, W.; Li, H.; Hui, D.; Gaff, M.; Lorenzo, R.; Corbi, I.; Ashraf, M. Effects of chemical modification and nanotechnology on wood properties. Nanotechnol. Rev. 2021, 10, 978–1008. [Google Scholar] [CrossRef]
- Liu, Q.; Gao, D.; Xu, W. Effect of Paint Process on the Performance of Modified Poplar Wood Antique. Coatings 2021, 11, 1174. [Google Scholar] [CrossRef]
- Susi, P.; Aktuganov, G.; Himanen, J.; Korpela, T. Biological control of wood decay against fungal infection. J. Environ. Manag. 2011, 92, 1681–1689. [Google Scholar] [CrossRef] [PubMed]
- Duan, X.; Liu, S.; Huang, E.; Shen, X.; Wang, Z.; Li, S.; Jin, C. Superhydrophobic and antibacterial wood enabled by polydopamine-assisted decoration of copper nanoparticles. Colloids Surf. A Physicochem. Eng. Asp. 2020, 602, 125145. [Google Scholar] [CrossRef]
- Hu, W.; Yang, Z.; Shi, N.; Yu, X. Experimental study on effects of the selected load parameters on fatigue life of the mortise-and-tenon furniture joint. Wood Mater. Sci. Eng. 2025, 19, 1–7. [Google Scholar] [CrossRef]
- Wang, C.; Li, J.; Wang, T.; Wang, X. Additive manufacturing of furniture corner guards based on thermoplastic polyurethane filament. BioResources 2025, 20, 5398–5406. [Google Scholar] [CrossRef]
- Liu, Y.; Hu, W.; Kasal, A.; Erdil, Y.Z. The state of the art of biomechanics applied in ergonomic furniture design. Appl. Sci. 2023, 13, 12120. [Google Scholar] [CrossRef]
- Xu, X.; Zhang, M.; Yue, X.; Xiong, X. Design of furniture mortise-and-tenon joints: A review of mechanical properties and design recommendations. Wood Mater. Sci. Eng. 2025, 1–15. [Google Scholar] [CrossRef]
- Yu, R.; Liu, Y.; Konukcu, C.A.; Hu, W. A method of simulating seat load for numerical analysis of wood chair structure. Wood Res. 2024, 69, 432–444. [Google Scholar] [CrossRef]
- Hu, W.; Yu, R.; Yang, P. Characterizing roughness of wooden mortise and tenon considering effects of measured position and assembly condition. Forests 2024, 15, 1584. [Google Scholar] [CrossRef]
- Fu, S.; Xiong, X.; Wan, R.; Zhang, M.; Xu, X. The Development and Future Challenges of China’s Furniture Industry. Drewno 2025, 68, 199709. [Google Scholar] [CrossRef]
- Hu, W.; Fu, W.; Zhao, Y. Optimal design of the traditional Chinese wood furniture joint based on experimental and numerical method. Wood Res. 2024, 69, 50–59. [Google Scholar] [CrossRef]
- Chang, C.W.; Lu, K.T. Synthesis and antibacterial activity of metal-containing ultraviolet-cured wood floor coatings. Polymers 2021, 13, 3022. [Google Scholar] [CrossRef]
- Xu, W.; Fang, X.Y.; Han, J.T.; Wu, Z.H. Effect of Coating Thickness on Sound Absorption Property of Four Wood Species Commonly Used for Piano Soundboards. Wood Fiber Sci. 2020, 52, 28–43. [Google Scholar] [CrossRef]
- Liu, Q.Q.; Gao, D.; Xu, W. Effect of Sanding Processes on the Surface Properties of Modified Poplar Coated by Primer Compared with Mahogany. Coatings 2020, 10, 856. [Google Scholar] [CrossRef]
- Liu, Q.Q.; Gao, D.; Xu, W. Effect of Polyurethane Non-Transparent Coating Process on Paint Film Performance Applied on Modified Poplar. Coatings 2022, 12, 39. [Google Scholar] [CrossRef]
- Hu, T.; Yuan, F.; Zhou, C.; Kaner, J. Effect of Innovative Office Furniture on Enhancing Employee Active Health. BioResources 2025, 20, 5200–5213. [Google Scholar] [CrossRef]
- Broda, M. Natural compounds for wood protection against fungi—A review. Molecules 2020, 25, 3538. [Google Scholar] [CrossRef]
- Liu, Q.Q.; Gu, Y.T.; Xu, W.; Lu, T.; Li, W.J.; Fan, H.B. Compressive Properties of Green Velvet Material Used in Mattress Bedding. Appl. Sci. 2021, 11, 11159. [Google Scholar] [CrossRef]
- Wan, R.Y.; Xiong, X.Q.; Fu, S.J.; Xiong, D.J.; Xu, X.T. Life cycle assessment and optimization scenarios of sofas: A case study in China. Int. J. Life Cycle Assess. 2025, 30, 2020–2036. [Google Scholar] [CrossRef]
- Wang, C.; Li, J.Y.; Wang, T.Y.; Chu, Q.; Wang, X.W. Fused deposition 3D printing of bonsai tree guiding mold based on acrylonitrile-butadiene-styrene copolymer. BioResources 2024, 19, 5839–5846. [Google Scholar] [CrossRef]
- Wang, C.; Li, J.Y.; Wang, T.Y.; Chu, Q.; Wen, S.Q. Design and Rapid Prototyping of Packaging Liner for Rosewood Craft based on Gyroid Infill Structure. BioResources 2025, 20, 842–851. [Google Scholar] [CrossRef]
- Abolhasani, H.; Farzi, G.; Davoodi, A.; Vakili-Azghandi, M.; Das, O.; Neisiany, R.E. Development of self-healable acrylic water-based environmental-friendly coating as an alternative to chromates coatings. Prog. Org. Coat. 2023, 176, 107402. [Google Scholar] [CrossRef]
- Han, K.; Liu, J.; Hao, F.; Wang, J.; Yuan, J.; Pan, Z.; Pan, M. An adaptive waterborne fluorocarbon coatings with Anti-Flashing Rust, Antibiofouling, and Self-Repairing properties. Chem. Eng. J. 2024, 495, 153644. [Google Scholar] [CrossRef]
- Wu, A.; Sun, Y.; Wang, Z.; Cao, G.; Zhang, H. Polyaniline/cellulose nanocrystal nanorods integrated into waterborne polyurethane coatings for enhanced corrosion resistance. Colloids Surf. A Physicochem. Eng. Asp. 2025, 713, 136531. [Google Scholar] [CrossRef]
- Mastouri, A.; Efhamisisi, D.; Tarmian, A.; Boukherroub, R.; Lexa, M.; Karami, E.; Frigione, M. Sustainable superhydrophobic and self-cleaning wood via wax within Epoxy/PDMS nano-composite coatings: Durability related to surface morphology. Prog. Org. Coat. 2024, 186, 107951. [Google Scholar] [CrossRef]
- Barthwal, S.; Uniyal, S.; Barthwal, S. Nature-inspired superhydrophobic coating materials: Drawing inspiration from nature for enhanced functionality. Micromachines 2024, 15, 391. [Google Scholar] [CrossRef]
- Zubko, M.K. Towards sustainable antimicrobials from plants: Some ways to abridge current methodological approaches. Sustain. Mater. Technol. 2024, 39, e00801. [Google Scholar] [CrossRef]
- Mercan, D.A.; Niculescu, A.G.; Grumezescu, A.M. Nanoparticles for antimicrobial agents delivery—An up-to-date review. Int. J. Mol. Sci. 2022, 23, 13862. [Google Scholar] [CrossRef] [PubMed]
- Zhang, H.L.; Li, Y.X. Antibacterial and Antimalarial Therapeutic Agents: A Patent Perspective. Recent Adv. Inflamm. Allergy Drug Discov. 2024, 18, 57–66. [Google Scholar] [CrossRef] [PubMed]
- Xiao, Q.Q.; Zhu, J.N.; Fang, T.; Peng, R.Y.; Chen, J.Y.; Liu, K.L.; Ceng, Y.S.; Yuan, M.; Hu, Y.R. Preparation and characterization of nano silver antibacterial gel for gynecolog. Ferroelectrics 2024, 618, 2249–2256. [Google Scholar] [CrossRef]
- Serwecińska, L. Antimicrobials and antibiotic-resistant bacteria: A risk to the environment and to public health. Water 2020, 12, 3313. [Google Scholar] [CrossRef]
- La Fauci, V.; Costa, G.B.; Genovese, C.; Palamara, M.A.R.; Alessi, V.; Squeri, R. Effect of Drug-Resistant Bacteria on Hands of Healthcare Workers and in the Patient Area: An Environmental Survey in Southern Italy’s Hospital. Rev. Española Quimioter. 2019, 32, 303. [Google Scholar]
- Nath, S.; Sinha, A.; Singha, Y.S.; Dey, A.; Bhattacharjee, N.; Deb, B. Effect of Prevalence of Antibiotic-Resistant, Toxic Metal-Tolerant and Biofilm-Forming Bacteria in Hospital Surroundings. Environ. Anal. Health Toxicol. 2020, 35, 2020018. [Google Scholar] [CrossRef]
- Cloutier, M.; Mantovani, D.; Rosei, F. Effect of Antibacterial Coatings: Challenges, Perspectives, and Opportunities. Trends Biotechnol. 2015, 33, 637–652. [Google Scholar] [CrossRef]
- Fu, Y.; Dudley, E.G. Effect of Antimicrobial-Coated Films as Food Packaging: A Review. Compr. Rev. Food Sci. Food Saf. 2021, 20, 3404–3437. [Google Scholar] [CrossRef]
- Valdés, A.; Ramos, M.; Beltrán, A.; Jiménez, A.; Garrigós, M.C. Effect of State of the Art of Antimicrobial Edible Coatings for Food Packaging Applications. Coatings 2017, 7, 56. [Google Scholar] [CrossRef]
- Yong, L.X.; Calautit, J.K. Effect of A Comprehensive Review on the Integration of Antimicrobial Technologies onto Various Surfaces of the Built Environment. Sustainability 2023, 15, 3394. [Google Scholar] [CrossRef]
- Mehta, N.; Kumar, P.; Verma, A.K.; Umaraw, P.; Kumar, Y.; Malav, O.P.; Sazili, A.Q.; Domínguez, R.; Lorenzo, J.M. Microencapsulation as a Noble Technique for the Application of Bioactive Compounds in the Food Industry: A Comprehensive Review. Appl. Sci. 2022, 12, 1424. [Google Scholar] [CrossRef]
- Wang, J.; Zhuang, S. Chitosan—Based Materials: Preparation, Modification and Application. J. Clean. Prod. 2022, 355, 131825. [Google Scholar] [CrossRef]
- Lobel, B.T.; Baiocco, D.; Al-Sharabi, M.; Routh, A.F.; Zhang, Z.; Cayre, O.J. Current Challenges in Microcapsule Designs and Microencapsulation Processes: A Review. ACS Appl. Mater. Interfaces 2024, 16, 40326–40355. [Google Scholar] [CrossRef]
- Zhang, H.; Wang, Z.; Qiu, H.; Xu, B.; Chen, K. Design and fabrication of silica/chitosan composite microcapsules for bifunctional fabric coating. Int. J. Biol. Macromol. 2025, 309, 143018. [Google Scholar] [CrossRef]
- Liu, J.; Liu, C.; Liu, Y.; Chen, M.; Hu, Y.; Yang, Z. Study on the grafting of chitosan–gelatin microcapsules onto cotton fabrics and its antibacterial effect. Colloids Surf. B Biointerfaces 2013, 109, 103–108. [Google Scholar] [CrossRef]
- Indriyani, N.N.; Al-Anshori, J.; Wahyudi, T.; Nurzaman, M.; Nurjanah, S.; Permadi, N.; Julaeha, E. An optimized chitosan/alginate-based microencapsulation of lime peel essential oil and its application as an antibacterial textile. J. Biomater. Sci. Polym. 2024, 35, 989–1007. [Google Scholar] [CrossRef]
- Karaaslan, M.; Şengün, F.; Cansu, Ü.; Başyiğit, B.; Sağlam, H.; Karaaslan, A. Gum arabic/maltodextrin microencapsulation confers peroxidation stability and antimicrobial ability to pepper seed oil. Food Chem. 2021, 337, 127748. [Google Scholar] [CrossRef]
- Velazquez-Martinez, V.; Valles-Rosales, D.; Rodriguez-Uribe, L.; Holguin, O.; Quintero-Quiroz, J.; Reyes-Jaquez, D.; Delgado, E. Antimicrobial, shelf-life stability, and effect of maltodextrin and gum arabic on the encapsulation efficiency of sugarcane bagasse bioactive compounds. Foods 2021, 10, 116. [Google Scholar] [CrossRef]
- Chang, Y.; Wu, Z.; Liu, E. Effect of Fabrication of Chitosan-Encapsulated Microcapsules Containing Wood Wax Oil on Antibacterial Self-Healing Wood Coatings. Ind. Crops Prod. 2024, 222, 119438. [Google Scholar] [CrossRef]
- Ma, L.; Xu, S. Effect of Investigation on the Restoration Properties of Wood Oil Microcapsules in Wood Coatings. Prog. Org. Coat. 2024, 197, 108853. [Google Scholar] [CrossRef]
- Liu, Y.; Li, L.; Zhao, A.; Song, X.; Wei, L.; Fang, M.; Zhu, X. Effect of Sustainable Fragrance Release Wax Oil Coating for Wood Substrate Based on Peppermint Essential Oil Microcapsules. Ind. Crops Prod. 2024, 208, 117848. [Google Scholar] [CrossRef]
- An, P.; Yang, X.; Yu, J.; Qi, J.; Ren, X.; Kong, Q. α-terpineol and terpene-4-ol, the critical components of tea tree oil, exert antifungal activities in vitro and in vivo against Aspergillus niger in grapes by inducing morphous damage and metabolic changes of fungus. Food Control 2019, 98, 42–53. [Google Scholar] [CrossRef]
- Mondello, F.; Fontana, S.; Scaturro, M.; Girolamo, A.; Colone, M.; Stringaro, A.; Ricci, M.L. Terpinen-4-ol, the main bioactive component of tea tree oil, as an innovative antimicrobial agent against Legionella pneumophila. Pathogens 2022, 11, 682. [Google Scholar] [CrossRef]
- Yadav, E.; Kumar, S.; Mahant, S.; Khatkar, S.; Rao, R. Tea tree oil: A promising essential oil. J. Essent. Oil Res. 2017, 29, 201–213. [Google Scholar] [CrossRef]
- Egbosiuba, T.C.; Abdulkareem, A.S.; Tijani, J.O.; Ani, J.I.; Krikstolaityte, V.; Srinivasan, M.; Veksha, A.; Lisak, G. Taguchi optimization design of diameter-controlled synthesis of multi walled carbon nanotubes for the adsorption of Pb(II) and Ni(II) from chemical industry wastewater. Chemosphere 2021, 266, 128937. [Google Scholar] [CrossRef]
- Moralı, U.; Demiral, H.; Şensöz, S. Optimization of activated carbon production from sunflower seed extracted meal: Taguchi design of experiment approach and analysis of variance. J. Clean. Prod. 2018, 189, 602–611. [Google Scholar] [CrossRef]
- QB/T 4373-2012; Surface Coating of Furniture—Technical Specification for Application of Waterborne Wood Coatings. Ministry of Industry and Information Technology of the People’s Republic of China: Beijing, China, 2012.
- ISO 20579-3:2021; Surface Chemical Analysis—Sample Handling, Preparation and Mounting Part 3: Biomaterials. International Standard Published: Geneva, Switzerland, 2021.
- GB/T 21866-2008; Test Method for Antibacterial Property and Antibacterial Effect of Antibacterial Coatings (Paint Films). Standardization Administration of the People’s Republic of China: Beijing, China, 2008.
- GB/T 4789.2-2022; Microbiological Examination of Food Hygiene—Aerobic Plate Count. Standardization Administration of the People’s Republic of China: Beijing, China, 2022.
- GB/T 11186.3-1989; Method for Measuring the Color of Painted Film—Part 3: Calculation of Color Difference. Standardization Administration of the People’s Republic of China: Beijing, China, 1989.
- GB/T 4893.6-2013; Physical and Chemical Performance Tests of the Paint Film on the Surface of Furniture—Part 6: Method for Determining Gloss. Standardization Administration of the People’s Republic of China: Beijing, China, 2013.
- ISO 2813: 2014; Paints and Varnishes—Determination of Gloss Value at 20°, 60° and 85°. International Standard Published: Geneva, Switzerland, 2014.
- ISO 25178-601:2025; Geometrical Product Specifications (GPS)—Surface Texture: Areal. International Standard Published: Geneva, Switzerland, 2025.
- ASTM D2370-16 (2021); Standard Test Method for Tensile Properties of Organic Coatings. American Society of Testing Materials: West Conshohocken, PA, USA, 2021.
- John Kennedy, J.P.K.; Muthuramalingam, J.B.; Balasubramanian, V.K.; Balakrishnan, M.; Murugan, K.; Ponnuchamy, K. Controlled Release of Urea Using Negatively Charged Polysaccharides. Polym. Adv. Technol. 2024, 35, e6508. [Google Scholar] [CrossRef]
- Ganie, S.A.; Naik, R.A.; Mir, T.A.; Ali, A.; Mazumdar, N.; Li, Q. Effect of Tailored Functionalization of Gum Arabic Iron (II) Complexes on Synthesis, Characterization and Dwindling of Antianemic Approach via In Vivo Studies. J. Polym. Environ. 2023, 31, 2448–2461. [Google Scholar] [CrossRef]
- Guan, Y.; Zhong, Q. Effect of Gum Arabic and Fe2+ on Synergistically Improving the Heat and Acid Stability of Norbixin at pH 3.0–5.0. J. Agric. Food Chem. 2014, 62, 12668–12677. [Google Scholar] [CrossRef]
- Pedaballi, S.; Li, C.C.; Song, Y.J. Dispersion of microcapsules for the improved thermochromic performance of smart coatings. RSC Adv. 2019, 9, 24175–24183. [Google Scholar] [CrossRef]
- Akram, S.; Bao, Y.; Butt, M.S.; Shukat, R.; Afzal, A.; Huang, J.Y. Fabrication and characterization of gum arabic-and maltodextrin-based microcapsules containing polyunsaturated oils. J. Sci. Food Agric. 2021, 101, 6384–6394. [Google Scholar] [CrossRef]
- Maleki, A.; Vafaeenezhad, H.; Eslami-Farsani, R. Polystyrene microcapsules containing linseed oil and SiC nanoparticles as a lubricant additive for boosting the self-healing and self-lubricating efficiency of epoxy coatings. Tribol. Int. 2024, 193, 109428. [Google Scholar] [CrossRef]
- Wu, Q.; Li, W.; Yan, X. Effect of Microcapsules on Mechanical, Optical, Self-Healing and Electromagnetic Wave Absorption Properties in Waterborne Wood Paint Coatings. Coatings 2023, 13, 1478. [Google Scholar] [CrossRef]
- Bollhorst, T.; Rezwan, K.; Maas, M. Effect of Colloidal Capsules: Nano-and Microcapsules with Colloidal Particle Shells. Chem. Soc. Rev. 2017, 46, 2091–2126. [Google Scholar] [CrossRef] [PubMed]
- Cunha, R.A.; Soares, T.A.; Rusu, V.H.; Pontes, F.J.; Franca, E.F.; Lins, R.D. The molecular structure and conformational dynamics of chitosan polymers: An integrated perspective from experiments and computational simulations. In The Complex World of Polysaccharides; IntechOpen: London, UK, 2012. [Google Scholar]
- Mohamed, S.A.; Elsherbini, A.M.; Alrefaey, H.R.; Adelrahman, K.; Moustafa, A.; Egodawaththa, N.M.; Sabra, S.A. Gum Arabic: A commodity with versatile formulations and applications. Nanomaterials 2025, 15, 290. [Google Scholar] [CrossRef] [PubMed]
- Tasios, N.; Samin, S.; Van Roij, R.; Dijkstra, M. Microphase separation in oil-water mixtures containing hydrophilic and hydrophobic ions. Phys. Rev. Lett. 2017, 119, 218001. [Google Scholar] [CrossRef] [PubMed]

| Test Materials | Purity | Manufacturer |
|---|---|---|
| Tea tree essential oil | - | Wuhan Huaxiang Biotechnology Co., Ltd., Wuhan, China |
| Chitosan | AR | Sinopharm Chemical Reagent Co., Ltd., Shanghai, China |
| Arabic gum | AR | Tianjin Kermel Chemical Reagent Co., Ltd., Tianjin, China |
| Tween-80 | AR | Sinopharm Chemical Reagent Co., Ltd., Shanghai, China |
| SDBS | AR | Shandong Xinjucheng Chemical Technology Co., Ltd., Jinan, China |
| Acetic acid | AR | Shandong Chengkai New Material Co., Ltd., Linyi, China |
| Sodium tripolyphosphate | AR | Tianjin Huasheng Chemical Reagent Co., Ltd., Tianjin, China |
| Dulux topcoat | - | Nanjing Jinyou Biotechnology Co., Ltd., Nanjing, China |
| Nutrient agar medium | - | Zhongshan Baimicrobial Technology Co., Ltd., Zhongshan, China |
| Nutrient broth medium | - | Zhongshan Baimicrobial Technology Co., Ltd., Zhongshan, China |
| Sodium chloride | AR | Sinopharm Chemical Reagent Co., Ltd., Shanghai, China |
| E. coli | - | Beijing Baocang Biotechnology Co., Ltd., Beijing, China |
| S. aureus | - | Beijing Baocang Biotechnology Co., Ltd., Beijing, China |
| Equipment | Model | Manufacturer |
|---|---|---|
| High-precision balance | BSA323S | Sartorius Scientific Instruments Co., Ltd., Beijing, China |
| Heat-collecting magnetic stirrer | DF-101S | Chuangyuan Instrument Manufacturing Co., Ltd., Zhengzhou, China |
| Spray dryer | JA-PWGZ100 | Hangzhou Feiyue Instrument Co., Ltd., Hangzhou, China |
| Blast drying oven | DHG-9423A | Shanghai Jinghong Experimental Equipment Co., Ltd., Shanghai, China |
| Scanning electron microscope | M360-HK822 | Shenzhen Oswald Optical Instrument Co., Ltd., Shenzhen, China |
| High-precision gloss metre | YG268 | Shenzhen 3nh Technology Co., Ltd., Shenzhen, China |
| Fourier transform infrared spectrometer | Agilent 5500 | Agilent Technologies (China) Co., Ltd., Beijing, China |
| Constant temperature and humidity box | THA150 | Nanjing Jinyou Biotechnology Co., Ltd., Nanjing, China |
| High-precision spectrophotometer | DC-23D | Shandong Yusuo Chemical Technology Co., Ltd., Linyi, China |
| Ultraviolet spectrophotometer | UV-2600i | Shimadzu (China) Co., Ltd., Shanghai, China |
| Universal mechanical testing machine | AGS-X | Shimadzu Manufacturing, Kyoto, Japan |
| Roughness metre | J8-4C | Shanghai Taiming Optical Instrument Co., Ltd., Shanghai, China |
| Ultrasonic emulsifier | XU-JY92-IIN | Shanghai Huxi Industry Co., Ltd., Shanghai, China |
| Circulating water vacuum pump | SHZ-D (III) | Shaoxing Xiniu Instrument Technology Co., Ltd., Shaoxing, China |
| Colony counter | XK97-A | Hangzhou Qiwei Instrument Co., Ltd., Hangzhou, China |
| Levels | Factor A Core–Wall Ratio | Factor B mAG:mCS | Factor C Emulsifier Concentration (%) | Factor D pH |
|---|---|---|---|---|
| 1 | 1.0:1 | 2:3 | 2 | 3 |
| 2 | 1.2:1 | 2:1 | 3 | 4 |
| 3 | 1.5:1 | 7:3 | 4 | 5 |
| Sample (#) | Factor A | Factor B | Factor C | Factor D |
|---|---|---|---|---|
| 1 | 1.0:1 | 2:3 | 2 | 3 |
| 2 | 1.0:1 | 2:1 | 3 | 4 |
| 3 | 1.0:1 | 7:3 | 4 | 5 |
| 4 | 1.2:1 | 2:3 | 3 | 5 |
| 5 | 1.2:1 | 2:1 | 4 | 3 |
| 6 | 1.2:1 | 7:3 | 2 | 4 |
| 7 | 1.5:1 | 2:3 | 4 | 4 |
| 8 | 1.5:1 | 2:1 | 2 | 5 |
| 9 | 1.5:1 | 7:3 | 3 | 3 |
| Sample (#) | CS-AG (% w/w) | TTO (% w/w) | Tween-80 (% w/w) | STPP (% w/w) | Acetic Acid (% v/v) |
|---|---|---|---|---|---|
| 1 | 1.25 | 1.25 | 1.00 | 0.20 | 1.00 |
| 2 | 2.50 | 2.25 | 1.50 | 0.20 | 1.00 |
| 3 | 2.50 | 3.00 | 2.00 | 0.20 | 1.00 |
| 4 | 1.25 | 1.50 | 1.50 | 0.20 | 1.00 |
| 5 | 2.50 | 3.00 | 2.00 | 0.20 | 1.00 |
| 6 | 2.50 | 3.00 | 1.00 | 0.20 | 1.00 |
| 7 | 1.25 | 1.88 | 2.00 | 0.20 | 1.00 |
| 8 | 2.50 | 3.75 | 1.00 | 0.20 | 1.00 |
| 9 | 2.50 | 3.75 | 1.50 | 0.20 | 1.00 |
| Sample (#) | Core–Wall Ratio (TTO:CS-AG) | CS (% w/w) | AG (% w/w) | TTO (% w/w) | STPP (% w/w) | Acetic Acid (% v/v) |
|---|---|---|---|---|---|---|
| 10 | 1.2:1 | 0.50 | 0.50 | 1.20 | 0.20 | 1.00 |
| 11 | 1.2:1 | 0.50 | 0.75 | 1.50 | 0.20 | 1.00 |
| 12 | 1.2:1 | 0.50 | 1.00 | 1.80 | 0.20 | 1.00 |
| 13 | 1.2:1 | 0.50 | 1.25 | 2.10 | 0.20 | 1.00 |
| 14 | 1.2:1 | 0.50 | 1.50 | 2.40 | 0.20 | 1.00 |
| 15 | 1.2:1 | 0.50 | 1.75 | 2.70 | 0.20 | 1.00 |
| Sample (#) | Factor A Core–Wall Ratio | Factor B mAG:mCS | Factor C Emulsifier Concentration (%) | Factor D pH | Output (g) | Yield (%) |
|---|---|---|---|---|---|---|
| 1 | 1.0:1 | 2:3 | 2 | 3 | 2.01 | 23.93 |
| 2 | 1.0:1 | 2:1 | 3 | 4 | 2.32 | 17.31 |
| 3 | 1.0:1 | 7:3 | 4 | 5 | 1.63 | 10.58 |
| 4 | 1.2:1 | 2:3 | 3 | 5 | 2.53 | 25.56 |
| 5 | 1.2:1 | 2:1 | 4 | 3 | 3.54 | 23.14 |
| 6 | 1.2:1 | 7:3 | 2 | 4 | 2.50 | 17.36 |
| 7 | 1.5:1 | 2:3 | 4 | 4 | 2.36 | 20.26 |
| 8 | 1.5:1 | 2:1 | 2 | 5 | 2.66 | 18.16 |
| 9 | 1.5:1 | 7:3 | 3 | 3 | 1.88 | 11.12 |
| k1 | 17.273 | 23.250 | 19.817 | 19.397 | ||
| k2 | 22.020 | 19.537 | 17.997 | 18.310 | ||
| k3 | 16.513 | 13.020 | 17.993 | 18.10 | ||
| R | 5.507 | 10.230 | 1.823 | 1.297 | ||
| Level | B > A > C > D | |||||
| Best Level | A2 | B1 | C1 | D1 | ||
| Best Process | A2 B1 C1 D1 | |||||
| Deviation Sum of Squares | 53.432 | 160.909 | 6.637 | 2.906 | ||
| Free Degree | 2 | 2 | 2 | 2 | ||
| F-Ratio | 0.955 | 2.875 | 0.119 | 0.052 | ||
| F-Critical Value | 4.460 | 4.460 | 4.460 | 4.460 | ||
| Significance | ||||||
| Sample (#) | Factor A Core–Wall Ratio | Factor B mAG:mCS | Factor C Emulsifier Concentration (%) | Factor D pH | Encapsulation Rate (%) |
|---|---|---|---|---|---|
| 1 | 1.0:1 | 2:3 | 2 | 3 | 70 |
| 2 | 1.0:1 | 2:1 | 3 | 4 | 60 |
| 3 | 1.0:1 | 7:3 | 4 | 5 | 45 |
| 4 | 1.2:1 | 2:3 | 3 | 5 | 60 |
| 5 | 1.2:1 | 2:1 | 4 | 3 | 65 |
| 6 | 1.2:1 | 7:3 | 2 | 4 | 50 |
| 7 | 1.5:1 | 2:3 | 4 | 4 | 70 |
| 8 | 1.5:1 | 2:1 | 2 | 5 | 55 |
| 9 | 1.5:1 | 7:3 | 3 | 3 | 70 |
| k1 | 58.333 | 66.667 | 58.333 | 68.333 | |
| k2 | 58.333 | 60.000 | 63.333 | 60.000 | |
| k3 | 65.000 | 55.000 | 60.000 | 53.333 | |
| R | 6.667 | 11.667 | 5.000 | 15.000 | |
| Level | D > B > A > C | ||||
| Best Level | A3 | B1 | C2 | D1 | |
| Best Process | A3 B1 C2 D1 | ||||
| Deviation Sum of Squares | 88.889 | 205.556 | 38.889 | 672.22 | |
| Free Degree | 2 | 2 | 2 | 2 | |
| F-Ratio | 0.529 | 1.223 | 0.231 | 2.017 | |
| F-Critical Value | 4.460 | 4.460 | 4.460 | 4.460 | |
| Significance | |||||
| Sample (#) | mAG:mCS | Yield (%) | Encapsulation Rate (%) |
|---|---|---|---|
| 10 | 1:1 | 27.72 | 63.3 |
| 11 | 1.5:1 | 36.34 | 53.3 |
| 12 | 2:1 | 17.24 | 66.7 |
| 13 | 2.5:1 | 35.19 | 63.3 |
| 14 | 3:1 | 31.98 | 60.0 |
| 15 | 3.5:1 | 12.86 | 60.0 |
| Sample (#) | Mean Grey Value | Evaluation |
|---|---|---|
| 0 | 129.64 | 0 |
| 12 | 146.44 | + |
| 13 | 134.84 | 0 |
| 14 | 137.73 | + |
| Sample (#) | E. coli (CFU/Piece) | Antimicrobial Rate (%) | Evaluation | S. Aureus (CFU/Piece) | Antimicrobial Rate (%) | Evaluation |
|---|---|---|---|---|---|---|
| 0 | 212 | 191 | ||||
| 10 | 152 | 28.32 | ++ | 70 | 63.36 | ++++ |
| 11 | 139 | 34.43 | ++ | 55 | 71.20 | ++++ |
| 12 | 109 | 48.56 | +++ | 49 | 74.33 | ++++ |
| 13 | 87 | 58.96 | +++ | 57 | 70.15 | ++++ |
| 14 | 72 | 65.55 | ++++ | 51 | 73.29 | ++++ |
| 15 | 131 | 38.21 | ++ | 42 | 77.47 | ++++ |
| Sample (#) | Chromaticity Value | ΔE | Evaluation | ||
|---|---|---|---|---|---|
| L | a | b | |||
| 0 | 85.21 | −0.11 | 5.93 | ||
| 10 | 83.11 | 1.41 | 16.93 | 7.59 | + |
| 11 | 81.77 | 0.83 | 16.69 | 7.56 | + |
| 12 | 82.41 | 0.27 | 14.86 | 6.40 | + |
| 13 | 84.48 | −0.26 | 10.55 | 3.49 | 0 |
| 14 | 83.85 | −0.56 | 10.14 | 3.30 | 0 |
| 15 | 84.18 | −0.58 | 11.43 | 4.09 | 0 |
| Sample (#) | Glossiness (GU) | Light Loss Rate (%) | Evaluation | ||||
|---|---|---|---|---|---|---|---|
| 20° | 60° | 85° | 20° | 60° | 85° | ||
| 0 | 16.20 | 29.30 | 37.10 | ||||
| 10 | 9.20 | 19.70 | 21.20 | 43.21 | 32.76 | 42.86 | -- |
| 11 | 8.70 | 18.80 | 22.00 | 46.30 | 35.84 | 40.70 | --- |
| 12 | 7.90 | 19.10 | 24.80 | 51.23 | 34.81 | 33.15 | -- |
| 13 | 8.60 | 20.10 | 29.00 | 46.91 | 31.40 | 21.83 | -- |
| 14 | 5.50 | 24.00 | 29.20 | 66.05 | 18.09 | 21.30 | -- |
| 15 | 6.00 | 18.30 | 21.20 | 62.96 | 37.54 | 42.86 | --- |
| Sample (#) | Transmittance (%) | Evaluation |
|---|---|---|
| 0 | 95.83 | 0 |
| 10 | 89.77 | - |
| 11 | 86.43 | - |
| 12 | 92.76 | 0 |
| 13 | 91.01 | - |
| 14 | 92.12 | 0 |
| 15 | 88.69 | - |
| Sample (#) | Average Surface Roughness (Ra, µm) | Evaluation |
|---|---|---|
| 0 | 0.080 | 0 |
| 10 | 0.618 | ---- |
| 11 | 0.605 | ---- |
| 12 | 0.428 | ---- |
| 13 | 0.419 | ---- |
| 14 | 0.422 | ---- |
| 15 | 0.579 | ---- |
| Sample (#) | Elongation (%) | Evaluation | σ (MPa) | Evaluation | E (GPa) | Evaluation |
|---|---|---|---|---|---|---|
| 0 | 21.04 | 0 | 4.86 | 0 | 0.23 | 0 |
| 10 | 4.73 | ---- | 3.00 | -- | 0.63 | ++++ |
| 11 | 7.41 | ---- | 4.41 | - | 0.60 | ++++ |
| 12 | 11.63 | --- | 3.66 | -- | 0.31 | ++ |
| 13 | 18.54 | - | 2.90 | --- | 0.16 | -- |
| 14 | 18.10 | - | 1.74 | ---- | 0.10 | --- |
| 15 | 6.29 | ---- | 4.30 | - | 0.68 | ++++ |
Disclaimer/Publisher’s Note: The statements, opinions and data contained in all publications are solely those of the individual author(s) and contributor(s) and not of MDPI and/or the editor(s). MDPI and/or the editor(s) disclaim responsibility for any injury to people or property resulting from any ideas, methods, instructions or products referred to in the content. |
© 2025 by the authors. Licensee MDPI, Basel, Switzerland. This article is an open access article distributed under the terms and conditions of the Creative Commons Attribution (CC BY) license (https://creativecommons.org/licenses/by/4.0/).
Share and Cite
Zhang, N.; Zhu, Y.; Yan, X.; Li, J. Preparation of Tea Tree Essential Oil@Chitosan-Arabic Gum Microcapsules and Its Effect on the Properties of Waterborne Coatings. Coatings 2025, 15, 1105. https://doi.org/10.3390/coatings15091105
Zhang N, Zhu Y, Yan X, Li J. Preparation of Tea Tree Essential Oil@Chitosan-Arabic Gum Microcapsules and Its Effect on the Properties of Waterborne Coatings. Coatings. 2025; 15(9):1105. https://doi.org/10.3390/coatings15091105
Chicago/Turabian StyleZhang, Nana, Ye Zhu, Xiaoxing Yan, and Jun Li. 2025. "Preparation of Tea Tree Essential Oil@Chitosan-Arabic Gum Microcapsules and Its Effect on the Properties of Waterborne Coatings" Coatings 15, no. 9: 1105. https://doi.org/10.3390/coatings15091105
APA StyleZhang, N., Zhu, Y., Yan, X., & Li, J. (2025). Preparation of Tea Tree Essential Oil@Chitosan-Arabic Gum Microcapsules and Its Effect on the Properties of Waterborne Coatings. Coatings, 15(9), 1105. https://doi.org/10.3390/coatings15091105
